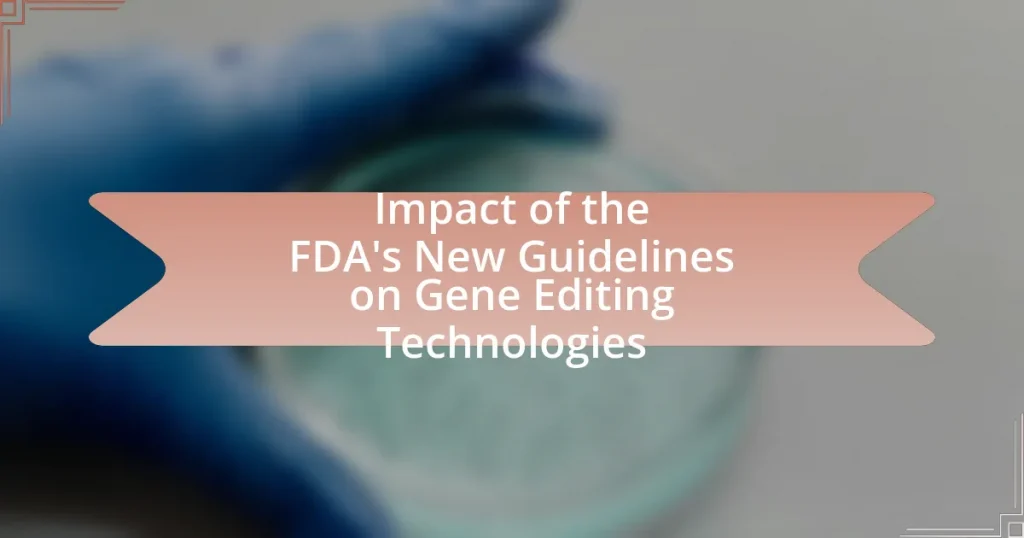

Posted inRegulatory Developments
The Role of International Regulations in Shaping Biotechnology Innovations
The article focuses on the critical role of international regulations in shaping biotechnology innovations. It outlines how these regulations establish safety standards, ethical guidelines, and frameworks for research and development,…